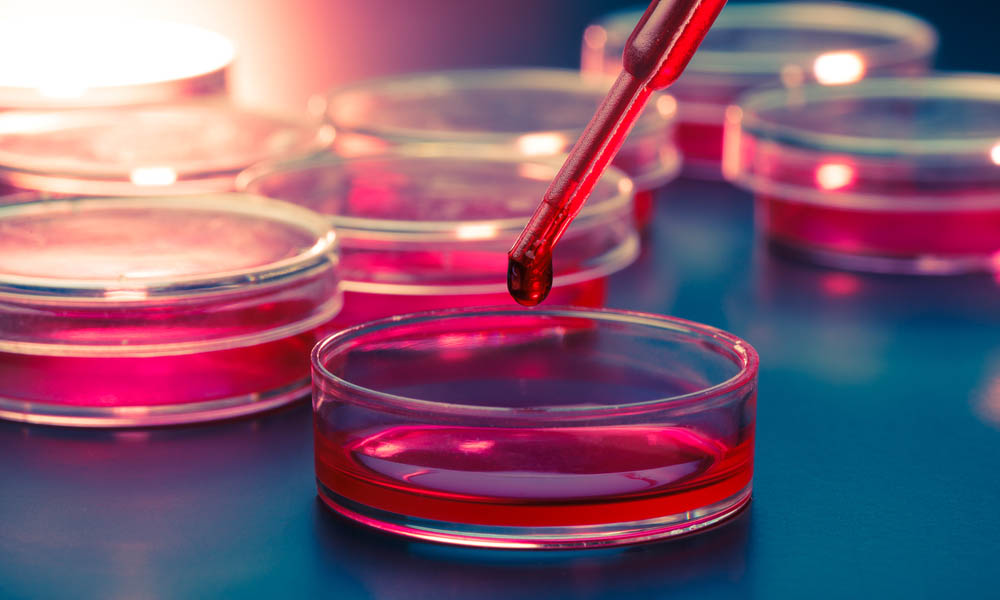

In unserem Labor produzieren wir Desoxy- und –Ribonukleotidtriphosphate (dNTP, NTP) und spezielle Nukleotidverbindungen (z.B. Mono- und Diphosphate) markiert mit 32P oder 33P und auch 35S-Methionin-Verbindungen. Bei allen Nukleotiden bestimmen Sie die Packungsgröße und wir pipettieren Ihre Wunschmenge.
Startseite
Portfolio
3H-, 14C-, 125I-Markierungen
Mehr als 10.000 3H- und 14C-markierte Produkte gehören zu unserem Portfolio. Schauen Sie in unseren Gesamtkatalog.
Primäre Isotope
Wir beliefern Sie kurzfristig mit 32P, 33P, 35S, 51Cr und 125I. Weitere Primärisotope stellen wir auf Anfrage bereit.
Peptidmarkierungen
De-Novo-Synthesen Ihrer gewünschten Sequenz mit 3H- oder 14C-markierten Aminosäuren führen wir in unserem Labor durch. Gerne beraten wir Sie auch bezüglich 125I-markierter Peptide.
Markierung von Oligonukleotiden/ DNA
Oligonukleotide und DNA markieren wir am 5‘-Ende, DNA alternativ auch per Random Priming oder Auffüllreaktion.
Sondersynthesen
Sondersynthesen 3H-, 14C- und 125I-markierter organischer Moleküle führen wir in unserem eigenen Labor, in Zusammenarbeit mit unserem sorgfältig ausgewählten Partnernetzwerk durch. Dabei greifen wir hier auf jahrzehntelange Erfahrung zurück.
Anwendungsgebiete
Unsere radioaktiven Chemikalien werden eingesetzt in der Grundlagenforschung und einer Vielzahl von weiteren Gebieten.
Im Folgenden sehen Sie eine kleine Auswahl.
Biochemie
Agrarforschung

Molekularbiologie

Genetik

Krebs- und HIV-Forschung

Tuberkulosebekämpfung
